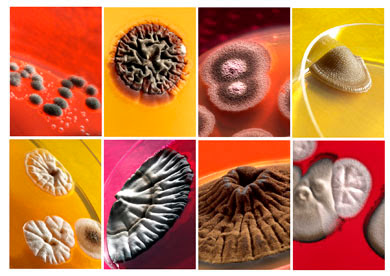

Microbiología
Concepto y Diversidad
La microbiología es la rama de la biología encargada del estudio de los microrganismos, seres vivos pequeños , también conocidos como microbios. Es la ciencia de la biología dedicada a estudiar los organismos que son sólo visibles a través del microscopio: organismos procariotas y eucariotas simples. Son considerados microbios todos los seres vivos microscópicos, estos pueden estar constituidos por una sola célula (unicelulares), así como pequeños agregados celulares formados por células equivalentes (sin diferenciación celular); estos pueden ser eucariotas (células con núcleo) tales como hongos y protistas, procariotas (células sin núcleo definido) como las bacterias . Sin embargo la microbiología tradicional se ha ocupado especialmente de los microorganismos patógenos entre bacterias, virus y hongos, dejando a otros microorganismos en manos de la parasitología y otras categorías de la biología.
Aunque los conocimientos microbiológicos de que se dispone en la actualidad son muy amplios, todavía es mucho lo que queda por conocer y constantemente se efectúan nuevos descubrimientos en este campo. Tanto es así que, según las estimaciones más habituales, sólo un 1% de los microbios existentes en la bioesfera han sido estudiados hasta el momento. Por lo tanto, a pesar de que han pasado más de 300 años desde el descubrimiento de los microorganismos, la ciencia de la microbiología se halla todavía en su infancia en comparación con otras disciplinas biológicas tales como la zoología, la botánica o incluso la entomología.
La microbiología estudia un conjunto heterogéno de organismos que tienen en común dos características fundamentales:
- Su tamaño microscópico
- La metodología de trabajo,cultivo,aislamiento y estudio.
Criterios de clasificación de los microorganismos
En el actual sistema de clasificación en cinco reinos, las bacterias pertenecen al reino Móneras, cuyos miembros son organismos procariotas, que se caracterizan porque las células carecen de un núcleo con una membrana diferenciada que lo rodee. Se conocen unas 1.600 especies. Las bacterias se suelen clasificar siguiendo varios criterios: por su forma, en cocos (esféricas), bacilos (forma de bastón), espiroquetas y espirilos (con forma espiral); según la estructura de la pared celular; por el comportamiento que presentan frente a la tinción de Gram; en función de que necesiten oxígeno para vivir o no (aerobias o anaerobias, respectivamente); según sus capacidades metabólicas o fermentadoras; por su posibilidad de formar esporas resistentes cuando las condiciones son adversas, y en función de la identificación serológica de los componentes de su superficie y de sus ácidos nucleicos.
La clasificación taxonómica más utilizada divide a las bacterias en cuatro grandes grupos según las características de la pared celular.
No todas las bacterias tienen capacidad de movimiento, pero las que lo hacen se desplazan gracias a la presencia de apéndices filamentosos denominados flagelos. Éstos pueden localizarse a lo largo de toda la superficie celular o en uno o ambos extremos, y pueden aparecer aislados o en grupo. Dependiendo de la dirección en que gire el flagelo, la bacteria puede moverse avanzando o agitándose en una dirección concreta. La duración de los movimientos de avance en relación con los de giro, está asociada a receptores presentes en la membrana bacteriana; estas variaciones permiten a la bacteria acercarse a determinadas sustancias, como partículas alimenticias, y alejarse de aquellas condiciones ambientales adversas. En algunas bacterias acuáticas, que contienen partículas ricas en hierro, el movimiento se orienta según el campo magnético.
Virus
Composición y estructura
La composición de un virus se refiere a su estado extracelular, conocido como partícula viral o virión, ya que en su estado intracelular su ácido nucleico se integra en la célula hospedadora y el virus desaparece temporalmente. Un virión está compuesto de ácido nucleico, enzimas, cápsida y en algunos casos envolturas membranosas externas.
El ácido nucleico, que representa solo el 1-2% del total del virión, es de un solo tipo, ADN o ARN, pudiendo ambos ser monocatenarios o bicatenarios, según estén formados por una o dos cadenas. Lo más frecuente es que forme una sola cadena, que puede estar abierta o cerrada (circular), pero también hay ácidos nucleicos fragmentados.
Las enzimas que contiene el virión son escasas. Le sirven para entrar o salir de la célula parasitada (lisozima y neuraminidasa) o para replicar o transcribir su ácido nucleico (polimerasas y transcriptasas).
Las enzimas que contiene el virión son escasas. Le sirven para entrar o salir de la célula parasitada (lisozima y neuraminidasa) o para replicar o transcribir su ácido nucleico (polimerasas y transcriptasas).
Figura 1-b: Virus del mosaico del tabaco
Figura 1-c: Virión icosaédrico
La cápsida es la cubierta proteica que protege al ácido nucleico. Es una estructura simétrica formada por la repetición de una reducida variedad de proteínas globulares conocidas como capsómeros.
Según la simetría de su cápsida los virus pueden ser:
- Helicoidales, como el virus del mosaico del tabaco. Sus capsómeros, dispuestos helicoidalmente, forman una especie de cilindro, en cuyo interior se aloja el ácido nucleico.
- Poliédricos, siendo los mas simples los icosaédricos con 20 caras triángulos equiláteros, cada uno de ellos formados por mas de un tipo de capsómero. Ejemplos el virus de las verrugas o el de la polio.
- Complejos, resultado de combinar las estructuras anteriores. Por ejemplo los bacteriófagos (virus que parasitan bacterias) constan de una cabeza icosaédrica con el ácido nucleico, una cola helicoidal que por medio de un cuello se une a una placa basal con espinas basales y fibras caudales por las que se fija a la bacteria.
Envolturas membranosas. En los virus envueltos la nucleocápsida (ácido nucleico más cápsida) está cubierta por una membrana, que es un fragmento de la célula en la que se reprodujo el virus, de la que pueden sobresalir proteínas o espículas. Los virus desnudos carecen de estas membranas.
Ciclo de vida: lítico y lisogénico
La producción de nuevas partículas virales es el único objetivo de los virus dado que como sabemos son formas acelulares e inanimadas en estado extracelular.
La multiplicación vírica es un complejo proceso que se divide en varias fases:
- Absorción o fijación a la célula hospedadora
Penetración
Tras la absorción de un virus a su hospedador, el virus completo o parte de él penetran en el interior de la célula. Los mecanismos de entrada pueden varias dependiendo tanto del tipo de virus como del tipo del tipo de hospedador:
- Algunos virus envueltos penetran por fusión de la cubierta vírica con la membrana plasmática celular y posterior vertido del contenido del virión dentro de la célula. (solo el ácido nucleico)
- Otros penetran por endocitosis al invaginarse la membrana celular e incluir al virión completo en una estructura conocida como endosoma, que a su vez puede fusionarse con un lisosoma celular para formar un fagolisosoma.
- La mayoría de los virus desnudos inyectan el ácido nucleico tras la unión de su cápsida a la membrana del hospedador.
- Otros entran directamente (penetración directa). Algunos fagos filamentosos se absorben a fimbrias específicas y tanto el ácido nucleico como las proteínas de la cápsida penetran al retraerse las fimbrias. Si el ácido nucleico penetra junto con las proteínas de la cápsida, estas deben ser eliminadas para que puedan acceder a él los enzimas necesarios para su replicación, transcripción y traducción. Este proceso llamado denudación se lleva a cabo generalmente por proteasas celulares, aunque también ayuda las variaciones de acidez del medio celular.
Síntesis de ácido nucleico y proteínas
Esta fase es el núcleo central de la multiplicación vírica y en ella se distinguen dos tareas principales: la síntesis de proteínas y la replicación del ácido nucleico. Para que ambos procesos tengan lugar es necesaria la producción de un ARNm, proceso que sigue distintos pasos dependiendo del tipo de ácido nucleico del virus.
Una vez sintetizado el ARNm, comienza el proceso de traducción. En primer lugar se forman las proteínas tempranas, que están implicadas en la replicación del ácido nucleico vírico. Después se sintetizan las proteínas tardías, que son generalmente estructurales. Para la síntesis de las primeras se usan enzimas de la célula hospedadora, aunque en algunos casos el virión posee alguno de los enzimas necesarios y los introduce en la célula en el proceso de penetración.
Una vez que se cuenta con los enzimas replicativos, se produce la replicación del ácido nucleico por mecanismos distintos según el tipo de virus. Los de ADN bicatenario se parece a la replicación de eucariotas y procariotas.
Todas las materias primas usadas (nucleótidos, Aa, lípidos y glúcidos) proceden de la célula hospedadora.
Ensamblaje
Una vez fabricados todos los componentes vírico se inicia la producción de los viriones. El ensamblaje es generalmente espontáneo en las condiciones ambientales óptimas. Esta espontaneidad se debe a la mayor estabilidad (menor energía libre) del virus completo que de los componentes independientes. El proceso es semejante a l plegamiento de las proteínas. En algunos virus el ensamblaje es dirigido por proteínas producidas a partir del genoma vírico que luego no aparecen en el virión.
Las partículas víricas formadas pueden salir de la célula de distintas formas:
v A causa de la muerte y desintegración celular (lisis) como consecuencia de la presencia de enzimas del virus que rompen las membranas celulares.
v Por lisis de la célula que contiene partículas víricas, debida al sistema inmunitario del hospedador.
v Por un proceso inverso al de la penetración directa.
v Por exocitosis uniéndose a la membrana celular en la que se han integrado proteínas víricas y liberándose los virus envueltos por gemación.
LISIS Y LISOGENIA
El ciclo de multiplicación que termina con la lisis celular recibe el nombre de ciclo lítico, y los virus que lo llevan a cabo son los virus virulentos. Sin embargo, hay otros virus capaces de permanecer en estado latente en la célula que parasitan, gracias a la integración del ADN vírico en el ADN celular; en este caso el ciclo se llama lisogénico. Estos últimos se llaman virus atemperados, y la forma integrada, provirus (o profago en el caso de virus bacterianos). Los virus con ciclo lisogénico mejor conocido son los bacterianos.
Ejemplo fago l
Este fago posee ADN bicatenario lineal con terminaciones monocatenarias complementarias (extremos cohesivos) que permiten su circularización. Una vez que el ácido nucleico está dentro de la bacteria E.coli, se produce el ARNm utilizando el enzima ARN polimerasa de la célula hospedadora.
Que siga un ciclo lítico o lisogénico depende de las concentraciones de determinadas proteínas represoras, como el represor de lambda y la proteína cro . Ambas proteínas regulan la expresión del ácido nucleico mediante la unión a operadores específicos. Si el represor es lo suficientemente abundante, impide que se expresen los genes que codifican el resto de las proteína víricas, pero no la expresión del gen int que codifica la integrasa, que permite la integración del ADN del fago bacteriano. Así, se replica con el ADN celular pasando a las generaciones siguientes. Bajo determinadas circunstancias se induce el ciclo lítico. Al soltarse del cromosoma bacteriano puede llevar unido parte de ese ADN, que puede introducir en la próxima célula que infecte.
Otros fagos no se integran en el ADN celular, sino que permanecen como moléculas de ADN bicatenario circular con capacidad autorreplicativa, similares a los plásmidos .
Bacterias
Concepto
Una bacteria es un organismo unicelular sin núcleo, y que es procariota. Las bacterias forman un dominio, en el esquema de tres dominios, bajo el reino Monera y se dividen en tres. Las más conocidas son las Eubacterias y las Archaea, pero la mayoría son Eubacteria.
Características estructurales
- Individualidad: Todas las células están rodeadas de una envoltura (que puede ser una bicapa lipídica desnuda, en células animales; una pared de polisacarido, en hongos y vegetales ; una membrana externa y otros elementos que definen una pared compleja, en bacterias Gram negativas ; una pared de peptidoglicano , en bacterias Gram positivas ; o una pared de variada composición, en arqueas que las separa y comunica con el exterior, que controla los movimientos celulares y que mantiene el potencial de membrana.
- Contienen un medio interno acuoso, el citosol, que forma la mayor parte del volumen celular y en el que están inmersos los orgánulos celulares.
- Poseen material genético en forma de ADN, el material hereditario de los genes y que contiene las instrucciones para el funcionamiento celular, así como ARN, a fin de que el primero se exprese.
- Tienen Enzimas y otras proteinas, que sustentan, junto con otras biomoléculas, un metabolismo activo.
Características funcionales
Las células vivas son un sistema bioquímico complejo. Las características que permiten diferenciar las células de los sistemas químicos no vivos son:
- Nutrición. Las células toman sustancias del medio, las transforman de una forma a otra, liberan energía y eliminan productos de desecho, mediante el metabolismo.
- Crecimiento y multipilcación. Las células son capaces de dirigir su propia síntesis. A consecuencia de los procesos nutricionales, una célula crece y se divide, formando dos células, en una célula idéntica a la célula original, mediante la división celular.
- Diferenciación. Muchas células pueden sufrir cambios de forma o función en un proceso llamado diferenciación celular. Cuando una célula se diferencia, se forman algunas sustancias o estructuras que no estaban previamente formadas y otras que lo estaban dejan de formarse. La diferenciación es a menudo parte del ciclo celular en que las células forman estructuras especializadas relacionadas con la reproducción, la dispersión o la supervivencia.
- Señalización. Las células responden a estímulos químicos y físicos tanto del medio externo como de su interior y, en el caso de células móviles, hacia determinados estímulos ambientales o en dirección opuesta mediante un proceso que se denomina quimiatosis. Además, frecuentemente las células pueden interaccionar o comunicar con otras células, generalmente por medio de señales o mensajeros químicos, como hormonas, neurotransmisores, factores de crecimiento... en seres pluricelulares en complicados procesos de comunicación celular y transducción de señales.
- Evolución. A diferencia de las estructuras inanimadas, los organismos unicelulares y pluricelulares evolucionan. Esto significa que hay cambios hereditarios (que ocurren a baja frecuencia en todas las células de modo regular) que pueden influir en la adaptación global de la célula o del organismo superior de modo positivo o negativo. El resultado de la evolución es la selección de aquellos organismos mejor adaptados a vivir en un medio particular.
Las propiedades celulares no tienen por qué ser constantes a lo largo del desarrollo de un organismo: evidentemente, el patrón de expresión de los genes varía en respuesta a estímulos externos, además de factores endógenos. Un aspecto importante a controlar es la pluripotencialidad, característica de algunas células que les permite dirigir su desarrollo hacia un abanico de posibles tipos celulares. En metazoos, la genética subyacente a la determinación del destino de una célula consiste en la expresión de determinados factores de transcripcion específicos del linaje celular al cual va a pertenecer, así como a modificaciones epigenéticas. Además, la introducción de otro tipo de factores de transcripción mediante ingenieria genética en células somáticas basta para inducir la mencionada pluripotencialidad, luego éste es uno de sus fundamentos moleculares.
Reproducción
En las bacterias, el aumento en el tamaño de las células (crecimiento) y la reproducción por división celular están íntimamente ligados, como en la mayor parte de los organismos unicelulares. Las bacterias crecen hasta un tamaño fijo y después se reproducen por fisión binaria, una forma de reproducción asexual. En condiciones apropiadas, una bacteria Gram-positiva puede dividirse cada 20–30 minutos y una Gram-negativa cada 15–20 minutos, y en alrededor de 16 horas su número puede ascender a unos 5.000 millones (aproximadamente el número de personas que habitan la Tierra). Bajo condiciones óptimas, algunas bacterias pueden crecer y dividirse muy rápido, tanto como cada 9,8 minutos. En la división celular se producen dos células hijas idénticas. Algunas bacterias, todavía reproduciéndose asexualmente, forman estructuras reproductivas más complejas que facilitan la dispersión de las células hijas recién formadas.
Por otro lado, cabe destacar un tipo de reproducción sexual en bacterias, denominada parasexualidad bacteriana. En este caso, las bacterias son capaces de intercambiar material genético en un proceso conocido como conjugación bacteriana. Durante el proceso una bacteria donante y una bacteria receptora llevan a cabo un contacto mediante pelos sexuales huecos o pili, a través de los cuales se transfiere una pequeña cantidad de ADN independiente o plásmido conjugativo. El mejor conocido es el plásmido F de E.Coli que además puede integrarse en el cromosoma bacteriano. En este caso recibe el nombre de episoma, y en la transferencia arrastra parte del cromosoma bacteriano. Se requiere que exista síntesis de ADN para que se produzca la conjugación. La replicación se realiza al mismo tiempo que la transferencia.
Tipos de nutrición
La nutrición de todos los organismos implica el aprovisionamiento de energía para llevar a cabo las reacciones metabólicas, y el suministro de materiales para la síntesis celular.En la nutrición heterótrofa, las reacciones catabólicas representan la forma de aprovisionamiento de energía, para lo cual es necesario que exista alguna molécula donadora de electrones para los procesos de producción energética, ya sea la fermentación o la respiración, esta última aerobia o anaerobia. Pero además, estos mismos nutrientes son los utilizados para los procesos de biosíntesis.En la nutrición autótrofa existe un paso previo, la fotosíntesis (quimiosíntesis), durante el cual el organismo fabrica sus propias moléculas orgánicas a partir de sustancias inorgánicas sencillas. Además, la energía necesaria para llevar a cabo esta síntesis se obtiene de dos fuentes diferentes: la energía solar o las reacciones químicas.El metabolismo bacteriano representa uno de los mayores puzzles para el estudiante de bioquímica, ya que presenta todos los tipos de nutrición posible, y todas las rutas metabólicas posibles. El análisis detallado de dichos metabolismos representa una prueba de fuego que mide el grado de comprensión alcanzado con respecto a los diferentes procesos metabólicos estudiados.
Clasificación metabolica de las bacterias
El metabolismo microbiano es el conjunto de procesos por los cuales un microorganismo obtiene la energía y los nutrientes (carbono, por ejemplo) que necesita para vivir y reproducirse. Los microorganismos utilizan numerosos tipos de estrategias metabolicas distintas y las especies pueden a menudo distinguirse en base a estas estrategias. Las características metabólicas específicas de un microorganismo constituyen el principal criterio para determinar su papel ecológico, su responsabilidad en los ciclos biogeoquímicos y su utilidad en los procesos industriales.
Microorganismos eucarióticos
Microorganismos eucarióticos
Enfermedades producidas por microorganismos:
|
Importancia de los microorganismos en investigación e industria
Diversos tipos de microorganismos son causantes de enfermedades a nivel de la historia y en el presente, los microorganismos son seres omnipresentes que se pueden encontrar en cualquier lugar, siendo de un alto nivel de importancia para la investigación de la medicina y diferentes campos. A nivel económico, por que estos microorganismos producen patologías o enfermedades a los animales, plantas, cosechas, , ganado, etc.
Durante el siglo XIX la atención de muchos naturalistas se había dirigido hacia las diferentes formas de animales y plantas que vivían como parásitos de otros organismos. Esta época fue muy relevante por que en esta época entro el campo MEDICO a revalorizarse las ideas sobre el origen germinal de las enfermedades infecciosas, la medicina entro a investigar y a realizar grandes investigaciones como la de AGOSTINO BASSI (1773-1856), demostró que la enfermedad del gusano, se debía a un hongo, por medio de este descubrimiento me puedo dar cuenta que los microorganismos fuero muy importantes para la medicina, ya que con todas las investigaciones que realizaron para discernir los microorganismos en cada uno de los reinos existentes fue definitivo y consecuente para las generaciones siguientes, ya que antes de que los grandes investigadores llegaran a una conclusión con sus diferentes tipos de patologías las personas morían por que no se le encontraba una cura para la enfermedad o mas bien una cura para frenar el desarrollo de los diversos microorganismos, ya que estos tienden a tener una reproducción muy desenfrenada.
Durante el siglo XIX la atención de muchos naturalistas se había dirigido hacia las diferentes formas de animales y plantas que vivían como parásitos de otros organismos. Esta época fue muy relevante por que en esta época entro el campo MEDICO a revalorizarse las ideas sobre el origen germinal de las enfermedades infecciosas, la medicina entro a investigar y a realizar grandes investigaciones como la de AGOSTINO BASSI (1773-1856), demostró que la enfermedad del gusano, se debía a un hongo, por medio de este descubrimiento me puedo dar cuenta que los microorganismos fuero muy importantes para la medicina, ya que con todas las investigaciones que realizaron para discernir los microorganismos en cada uno de los reinos existentes fue definitivo y consecuente para las generaciones siguientes, ya que antes de que los grandes investigadores llegaran a una conclusión con sus diferentes tipos de patologías las personas morían por que no se le encontraba una cura para la enfermedad o mas bien una cura para frenar el desarrollo de los diversos microorganismos, ya que estos tienden a tener una reproducción muy desenfrenada.
En la agricultura son de gran importancia, ya que muchos de estos organismos son los causantes de gran cantidad de enfermedades, llegando a perderse las cosechas.
Algunas propiedades son benéficas, como las bacterias fijadoras de nitrógeno (micorrizas).
En la industria muchos de estos microorganismos son los encargados de la producción de vinagre, cerveza, vino, alcohol, etc.
En la salud por la producción de antibioóticos y vacunas: penicilina, etc
Algunas propiedades son benéficas, como las bacterias fijadoras de nitrógeno (micorrizas).
En la industria muchos de estos microorganismos son los encargados de la producción de vinagre, cerveza, vino, alcohol, etc.
En la salud por la producción de antibioóticos y vacunas: penicilina, etc
Biotecnología
La biotecnología ha sido utilizada por el hombre desde los comienzos de la historia en actividades tales como la preparación del pan y de bebidas alcohólicas o el mejoramiento de cultivos y de animales domésticos. Procesos como la producción de cerveza, vino, queso y yogurt implican el uso de bacterias o levaduras con el fin de convertir un producto natural como la leche, en un producto de fermentación más apetecible como el yogurt.
En términos generales biotecnología es el uso de organismos vivos o de compuestos obtenidos de organismos vivos para obtener productos de valor para el hombre.
La biotecnología moderna está compuesta por una variedad de técnicas derivadas de la investigación en biología celular y molecular, que pueden ser utilizadas en cualquier industria que utilice microorganismos o células vegetales o animales.
Por tanto, podemos decir que la biotecnología abarca desde la biotecnología tradicional, muy conocidas y ser utilizadas, desde la fermentación de alimentos, hasta la biotecnología moderna, basada en la utilización de las nuevas técnicas del ADN (ingeniería genética), los anticuerpos monoclonales y los nuevos métodos de cultivo de células y tejidos.
· Descubrimientos clave para el desarrollo de la biotecnología:
1928-Fleming descubre la penicilina y se produce masivamente en la Segunda Guerra Mundial.
1953-El bioquímico americano James Watson y el biofísico Francis Crick anuncian la estructura en doble hélice del ADN o código genético.
1960-Severo Ochoa hace copias del material genético en laboratorio y descubre el código genético, descifra la clave en la que están escritos los mensajes del material genético.
1978- Se descubren las enzimas de restricción, que cortan el material genético por lugares determinados.
Se clonó el gen de la insulina humana.
1983- Se desarrolla la primera planta mediante ingeniería genética, a partir de una planta del tabaco
- Se inventa la técnica PCR (reacción en cadena de la polimerasa), que permite copiar genes específicos con gran rapidez. Es una técnica muy poderosa para producir millones de copias de una región específica de ADN, que permite analizarla tan rápido como se puede purificar una sustancia química. PCR ha sido el instrumento esencial en el desarrollo de técnicas de diagnóstico, medicina forense y la detección de genes asociados con errores innatos del metabolismo.
1988-La Universidad de Harvard patenta por primera vez un organismo producido mediante ingeniería genética, un ratón.
Se crea la organización HUGO para llevar a cabo el Proyecto Genoma Humano: identificar todos los genes del cuerpo humano.
· Historia de la biotecnología:
La biología no es nueva, desde hace miles de años, nuestros orígenes, durante la Edad de Piedra, empezaron la práctica de utilizar organismos vivos y sus productos.
La biotecnología es un término que se ha dado a la evolución y recientes avances de la ciencia de la genética. Esta ciencia se originó hacia finales del siglo XX con el trabajo de Mendel.
En términos generales biotecnología es el uso de organismos vivos o de compuestos obtenidos de organismos vivos para obtener productos de valor para el hombre.
La biotecnología moderna está compuesta por una variedad de técnicas derivadas de la investigación en biología celular y molecular, que pueden ser utilizadas en cualquier industria que utilice microorganismos o células vegetales o animales.
Por tanto, podemos decir que la biotecnología abarca desde la biotecnología tradicional, muy conocidas y ser utilizadas, desde la fermentación de alimentos, hasta la biotecnología moderna, basada en la utilización de las nuevas técnicas del ADN (ingeniería genética), los anticuerpos monoclonales y los nuevos métodos de cultivo de células y tejidos.
· Descubrimientos clave para el desarrollo de la biotecnología:
1928-Fleming descubre la penicilina y se produce masivamente en la Segunda Guerra Mundial.
1953-El bioquímico americano James Watson y el biofísico Francis Crick anuncian la estructura en doble hélice del ADN o código genético.
1960-Severo Ochoa hace copias del material genético en laboratorio y descubre el código genético, descifra la clave en la que están escritos los mensajes del material genético.
1978- Se descubren las enzimas de restricción, que cortan el material genético por lugares determinados.
Se clonó el gen de la insulina humana.
1983- Se desarrolla la primera planta mediante ingeniería genética, a partir de una planta del tabaco
- Se inventa la técnica PCR (reacción en cadena de la polimerasa), que permite copiar genes específicos con gran rapidez. Es una técnica muy poderosa para producir millones de copias de una región específica de ADN, que permite analizarla tan rápido como se puede purificar una sustancia química. PCR ha sido el instrumento esencial en el desarrollo de técnicas de diagnóstico, medicina forense y la detección de genes asociados con errores innatos del metabolismo.
1988-La Universidad de Harvard patenta por primera vez un organismo producido mediante ingeniería genética, un ratón.
Se crea la organización HUGO para llevar a cabo el Proyecto Genoma Humano: identificar todos los genes del cuerpo humano.
· Historia de la biotecnología:
La biología no es nueva, desde hace miles de años, nuestros orígenes, durante la Edad de Piedra, empezaron la práctica de utilizar organismos vivos y sus productos.
La biotecnología es un término que se ha dado a la evolución y recientes avances de la ciencia de la genética. Esta ciencia se originó hacia finales del siglo XX con el trabajo de Mendel.

mejoraría mucho con un buen aspecto gráfico.
ResponderEliminar